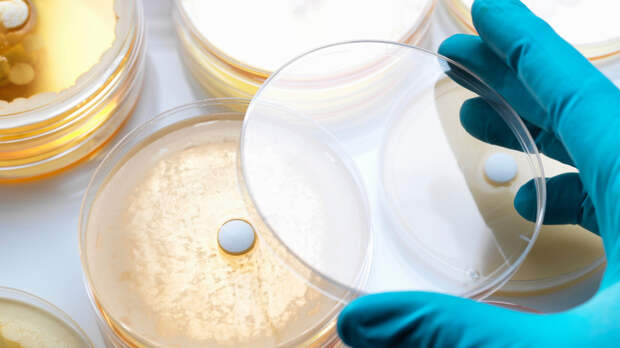

Пищевые отравления, вызванные стафилококком, чаще всего связаны с употреблением белковых продуктов, таких как торты и пирожные с кремами. Об этом в беседе с RT заявил специалист по особо опасным инфекциям доктор медицинских наук Владислав Жемчугов.
«Продукты, которые наиболее подвержены, — это белковые продукты, то есть это кремы яичные, белковые, сметанные.
Именно торты или пирожные наиболее часто вызывают стафилококковое отравление», — пояснил эксперт.Собеседник RT уточнил, что опасность представляет токсин, который он вырабатывает, размножаясь в пище. Именно этот токсин вызывает тяжёлые симптомы — рвоту и тошноту.
Главной причиной распространения таких инфекций врач назвал нарушение технологии приготовления и хранения пищи в системе общепита.
«Промышленная технология приготовления пищи требует колоссальной аккуратности, соблюдения регламента на всех путях, начиная от нарезки и мытья продуктов до их смешивания, хранения и транспортировки. Если где-то что-то нарушено, то возникает вероятность того, что люди получат тяжёлое отравление», — предупредил Жемчугов.
Для безопасности потребителей специалист посоветовал внимательно следить за сроками годности и условиями хранения готовой продукции в магазинах.
«Если видите, что лежит салат с мясом, с яйцом или со сметаной и там стоит температура +10° — идите отсюда подальше», — резюмировал он.
Ранее стало известно, что в калининградском кафе, где отравились 14 детей, нашли кишечную палочку и стафилококк.
Свежие комментарии